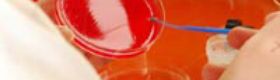

EHPAD
Prendre soin des résidents : la relation au cœur de la prévention
L’état de santé des résidents en établissement d’hébergement pour personnes âgées dépendantes (EHPAD) nécessite des soins accrus, avec une prise en charge adaptée à des troubles cognitifs majeurs. Ces facteurs ont un impact sur la qualité relationnelle de la prise en charge. Ils exposent les professionnels de ces structures à une charge physique et psychologique importante. La prévention doit tendre à soulager la pénibilité physique et à éviter l’épuisement professionnel.
Un aperçu du quotidien des professionnels travaillant dans un EHPAD
On dénombre aujourd’hui près de 7 500 EHPAD en France et plus de 350 000 personnels dédiés à la prise en charge des résidents : aides-soignants, infirmiers, cadres de santé, psychomotriciens, ergothérapeutes, aides médico-psychologiques (AMP)… Mais ces structures font intervenir une grande diversité de métiers au-delà des soins : personnels de cuisine, agents hôteliers, agents de direction, lingers… Ils ont tous pour mission d’accompagner des personnes âgées dont le niveau de dépendance ne permet plus qu’elles restent seules à leur domicile.
Ces structures accueillent également de « nouveaux » publics : personnes handicapées vieillissantes, personnes âgées atteintes de troubles psychiatriques, conduites addictives… À noter par ailleurs que plus de 90 % des résidents souffrent d’affections neuropsychiatriques (syndrome démentiel, état dépressif, trouble du comportement), et que 70 % ont besoin d’aide pour s’alimenter.
Attention : cette page est centrée principalement sur les risques auxquels sont exposés les travailleurs dédiés à la prise en charge des résidents. Le chef d’établissement devra prendre en compte les risques auxquels sont exposés d’autres activités : entretien et maintenance, restauration, lingerie, logistique, transport de résidents…
Évaluation des risques
Sous la responsabilité de l’employeur, les risques doivent être évalués et un document unique rédigé. Lors de ce travail, un temps d’échange entre l’encadrement et le personnel permet :
- de parvenir à un constat partagé sur les risques professionnels auxquels les intervenants sont exposés,
- d’élaborer de façon concertée des actions de prévention,
- d’être informés des difficultés organisationnelles, techniques ou humaines rencontrées pour envisager ensemble des solutions.
Principaux risques professionnels
La grande dépendance physique des résidents implique une aide au transfert importante par les soignants. Le recours aux aides techniques est le plus souvent inadéquat : défaut de formation à leur utilisation, équipement inadapté… Il en résulte :
- des lésions liées aux manutentions manuelles, qui représentent près des 2/3 des accidents du travail (plus d’1/3 le dos, près d’1/3 les membres supérieurs).
- une quasi-totalité de maladies professionnelles concernant les troubles musculosquelletiques (TMS).
Les déplacements nombreux, sur de longues distance et sur plusieurs étages, parfois dans la précipitation et dans des espaces souvent exigus, génèrent par ailleurs de nombreuses chutes de plain-pied et chutes de hauteur.
Dans ces métiers, la charge émotionnelle est conséquente :
- Le travail émotionnel est particulièrement prégnant : accompagnement en fin de vie, troubles cognitifs des résidents générant agressivité, violence verbale et physique, et altération de la relation à autrui… S’ajoute à cela la crainte du risque d’errance ou de sortie non autorisée si le résident n’est pas en secteur fermé.
- Une frustration des soignants est souvent déclarée, les tâches de soins, nursing, hygiène de base… ayant tendance à augmenter au détriment du travail relationnel et du maintien de l’autonomie du résident. La technicisation du travail et l’emprise trop importante du suivi administratif sont également mises en cause.
Ce travail émotionnel soutenu, associé à un sentiment de frustration, expose particulièrement les soignants à un risque d’épuisement professionnel.
Par ailleurs, les EHPAD sont des établissements d’accueil médicalisé. Au même titre que dans un établissement de soins, les professionnels sont donc exposés aux risques infectieux et aux risques chimiques.
Pistes de prévention prioritaires
Les actions de prévention doivent porter prioritairement sur l’allègement des manutentions manuelles et la place du « prendre soin » dans l’activité des personnels. Ce qui implique notamment d’intégrer la prévention des risques professionnels le plus en amont possible, à l’occasion d’une rénovation ou de la conception de nouveaux locaux et de l’acquisition de nouveaux équipements.
Par exemple, il est indispensable de concevoir / rénover des locaux de façon à permettre l’intégration des aides techniques dans les soins :
- équipement de toutes les chambres d’un rail plafonnier (sur lequel peut être installé un moteur fixe), en H de préférence pour couvrir une zone de transfert la plus large possible incluant la salle de bains,
- choix de revêtements de sols permettant de déplacer sans effort les aides techniques mobiles (éviter notamment les revêtements mous). Sont disponibles sur le marché des revêtements durs qui absorbent le bruit et qui amortissent les chutes,
- implantation d’espaces de stockage des aides techniques au plus près des lieux d’utilisation.
Le recours aux aides techniques est en effet indispensable pour préserver la santé et la sécurité des soignants. Encore faut-il bien les choisir et bien former les soignants à leur intégration naturelle dans les soins qu’ils prodiguent.
Éviter les chutes est également un axe de prévention important. Pour cela, le responsable de structure sera vigilant à anticiper cette problématique lors de la conception ou de la rénovation de son établissement, pour limiter :
- le nombre et l’amplitude des déplacements,
- les dénivellations,
- les seuils et les obstacles au sol.
Il doit privilégier des revêtements de sols anti-dérapants dans toutes les zones à risques d’éclaboussure (cuisine, salle de bain…). Il doit enfin équiper les personnels de chaussures fermées antidérapantes.
Une série de mesures est à mettre en place pour réduire le sentiment de frustration évoqué plus haut, pour prévenir l’épuisement professionnel et remettre la qualité des soins au premier plan :
- Intégrer dans l’organisation la dimension du relationnel dans la relation de soins.
- Former les soignants à la prise en charge de résidents atteints de troubles cognitifs.
- Donner les moyens aux soignants d’intégrer des aides techniques dans les soins pratiqués, pour leur permettre de se concentrer sur le relationnel avec le résident et sur le maintien de son autonomie.
Prévention des TMS dans le secteur de l'aide et du soin à la personne
La démarche ALM (accompagner la mobilité de la personne aidée en prenant soin de l’autre et de soi) est la solution de prévention des risques de TMS liés à la manutention des patients. Une série de dix films courts illustre plusieurs exemples de sa mise en œuvre dans l’accompagnement de déplacements, par exemple aider une personne à remonter dans son lit, à se lever de son fauteuil, s'y asseoir…
Le risque infectieux, une attention permanente
Le respect des précautions « standard » constitue la base des mesures de prévention des risques infectieux. Le principe est de considérer chaque résident comme porteur potentiel d’agents infectieux. Ces précautions doivent être appliquées systématiquement par l’ensemble des professionnels pour tous les résidents, quel que soit leur statut sérologique et leur état de santé. Elles concernent notamment l'hygiène des mains et, en fonction des tâches effectuées, le port de gants et de vêtements de protection, la manipulation des piquants, tranchants, la gestion des déchets de soins et du linge souillé, le transport des prélèvements. Des mesures complémentaires sont ajoutées au cas par cas en fonction de la pathologie du résident et des différents modes de transmission (aérosol, gouttelettes ou contact), en concertation avec le médecin coordonnateur et/ou l’infirmier coordonnateur qui s’occupe du résident.
La conduite à tenir après un accident exposant au sang (AES) ou d’exposition fortuite à des agents infectieux (grippe, coqueluche, gale, tuberculose…) doit être connue de toute personne potentiellement exposée : premiers soins à faire d’urgence, prise d’un avis médical pour l’évaluation du risque… Le protocole doit être affiché en salle de soins (avec le nom du médecin référent…).
Un suivi en santé au travail est nécessaire notamment pour rappeler les mesures de prévention et pour vérifier les vaccinations.
Le risque chimique à ne pas oublier
De nombreux produits sont utilisés dans les EHPAD : détergents, détergents désinfectants, désinfectants… La principale mesure de prévention consiste à former les intervenants à l’utilisation des produits chimiques en se référant aux fiches de données de sécurité, en appliquant les protocoles en vigueur dans l’établissement et en rappelant l’importance de ne jamais mélanger les produits.
Pour en savoir plus
-
Brochures INRS
-
Dépliant 11/2024 | ED 6415

-
Brochure 06/2024 | ED 6099

-
Dépliant 01/2020 | ED 6242

EHPAD. Préserver la santé des personnels tout en optimisant la qualité des soins
-
Brochure 06/2017 | ED 6291

-
Dépliant 04/2020 | ED 6375

-
Brochure 02/2019 | ED 4701

-
Brochure 01/2020 | ED 6150

Travailler avec des produits chimiques. Pensez prévention des risques !
-
Brochure 04/2020 | ED 4703

-
Dépliant 11/2024 | ED 6415

-
Dépliant 03/2021 | ED 6414

Guide de choix. Acquisition de chariots ou d'aides à la manutention de personnes
-
-
Affiches
-
Outils INRS
-
Outil Logiciel en ligne

Outil Faire le point RPS pour le secteur sanitaire et social
-
-
Videos INRS
-
Vidéo Durée : 10min 29s

-
Vidéo Durée : 10min 25s

-
-
Formation
-
Articles de revues INRS
-
Article de revue 03/2022

Les établissements d’hébergement pour personnes âgées dépendantes
-
Article 03/2020 | DC 26

-
-
Secteurs connexes
-

-

-
04/2026

-
04/2026

-
DOSSIER
-
-
Dossiers
-
DOSSIER 01/2015

-
01/2022

-
DOSSIER 09/2024

-
dossier 02/2023

-
dossier 01/2023

-
Dossier 06/2025

-
-
Lien utile




















